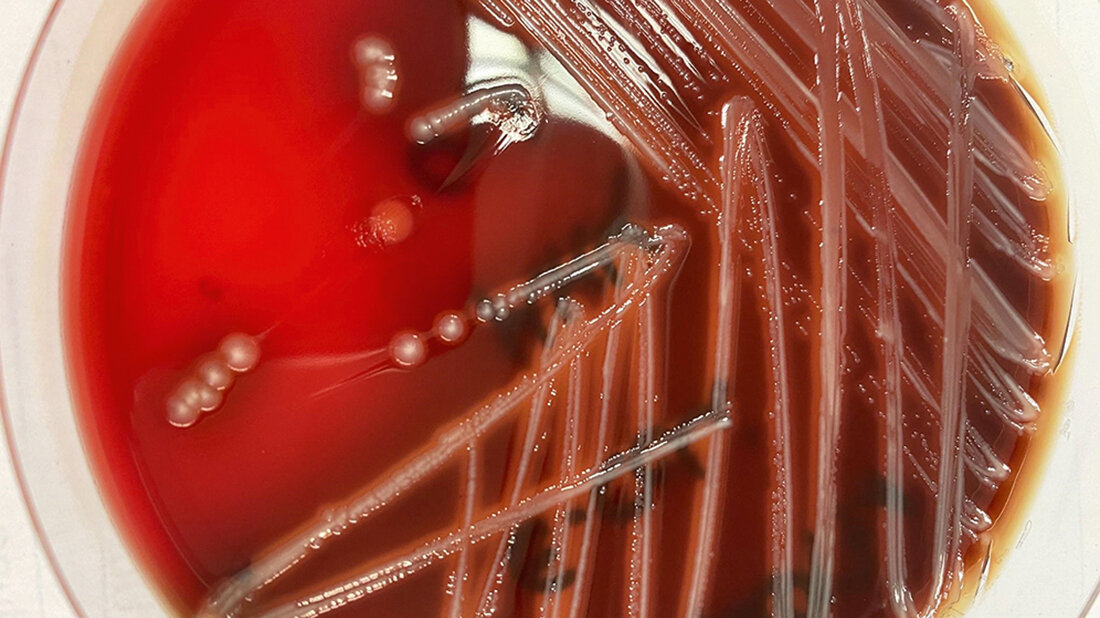
Hämolysierender E. coli auf Blutagar

Diagnostik von Durchfallerregern der Bakteriologie am Beispiel von Escherichia coli
Die in das Chemische und Veterinäruntersuchungsamt Freiburg integrierte Berufsfachschule für Veterinärmedizinisch-technische Assistenten/-innen hat die verantwortungsvolle Aufgabe, für das gesamte Land kompetentes Fachpersonal auszubilden. So kann gewährleistet werden, dass Baden-Württemberg auch in Zukunft im Bereich der Tiergesundheit und dem Verbraucherschutz gut aufgestellt ist. Die Schule verfügt über eine mehr als 60-jährige Tradition und hat schon über 750 jungen Menschen den erfolgreichen Einstieg in einen vielfältigen und bedeutsamen Beruf ermöglicht. Aktuell absolvieren an der VMTA-Schule Freiburg 18 Schüler/-innen die Ausbildung zur/zum Veterinärmedizinisch-technischen Assistent/-in. Im Rahmen eines fächerübergreifenden Projekts zur Diagnostik von Durchfallerregern erarbeiteten die Schüler/-innen der Abschlussklasse 2022 die nachfolgenden Artikel. Das Thema „Durchfallerreger“ wurde anhand von Beispielen aus den Fachbereichen Virologie, Bakteriologie, Parasitologie und Lebensmittel-Mikrobiologie betrachtet. Die Artikel der jeweiligen Sachgebiete wurden jeweils in Partnerarbeit von 2 Schüler/-innen verfasst. Jedem Schülerteam wurde ein hausinterner Experte des betreffenden Sektors als Mentor zur Verfügung gestellt.
Einleitung
Innerhalb der Gattung Escherichia, aus der Familie Enterobacteriaceae, ist Escherichia coli die bedeutsamste Bakterienart. Es sind gramnegative, gerade Stäbchen (Größe: 1,1–1,5 x 2,0–6,0 µm), welche beweglich, peritrich begeißelt und zum Teil kapselbildend sind. Die Gattung wurde nach dem deutschen Kinderarzt und Entdecker Theodor Escherich benannt.
E. coli können sowohl pathogen als auch apathogen sein. Die nicht pathogenen Stämme sind Bestandteil der normalen Darmflora bei Mensch und Tier. Pathogene Stämme können in intestinale pathogene E. coli (InPEC) und extraintestinale pathogene E. coli (ExPEC) unterteilt werden. Die intestinalen Stämme verursachen schwerwiegende Durchfallerkrankungen, während die extraintestinalen Stämme verschiedene Infektionen außerhalb des Darmtraktes, wie beispielsweise Harnwegsinfektionen oder Wundinfektionen, bei Mensch und Tier auslösen. Die wichtigsten intestinalen Stämme für die Tierart Schwein, enteropathogene E. coli (EPEC), enterotoxische E. coli (ETEC) und Shigatoxin-bildende E. coli (STEC), sind in der Tabelle dargestellt. Die hohe Variabilität der E. coli zeigt die gute Anpassungsfähigkeit an die unterschiedlichen Habitate. Zudem verfügen sie über verschiedene Virulenzfaktoren, welche durch horizontalen Gentransfer an andere Stämme weitergegeben werden.
Entnommen aus MTA Dialog 2/2022
Dann nutzen Sie jetzt unser Probe-Abonnement mit 3 Ausgaben zum Kennenlernpreis von € 19,90.
Jetzt Abonnent werden